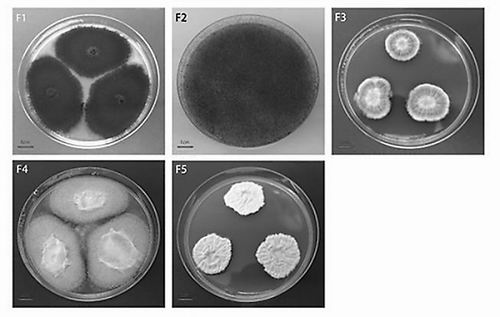

为啥瓜子外壳完好却“败絮其中”
内霉葵花籽中分离到的真菌菌落:F1为链格孢属菌(优势菌);F2为根霉;F3为萨氏曲霉;F4为黄曲霉;F5为白曲霉。课题组供图
■本报见习记者 王敏
葵花籽是生活中常见的休闲零食,嗑瓜子时突然吃到一颗“霉”瓜子,是很多人都经历过的不适体验。你有没有想过,外壳看着明明很正常的葵花籽为什么会发霉?如何预防发霉?
近日,中国科学院合肥物质科学研究院智能机械研究所(以下简称智能所)研究员吴跃进课题组首次揭示了葵花籽内部霉变发生机制,并提出控制霉菌生长和传播食物链的防治措施,为葵花籽等坚果类内部霉变机制研究和防控提供重要模式参考。相关成果发表于《微生物》。
隐藏的霉菌
葵花籽富含不饱和脂肪酸、蛋白质、多种维生素和微量元素,通常被直接食用或用于提取食用油。中国是继乌克兰、俄罗斯和阿根廷之后的全球第四大葵花籽生产国。
“大部分发生内霉的葵花籽外壳正常,很难被肉眼或色选设备识别,导致消费者误食,影响对美食的消费体验,也危害人体健康。”论文通讯作者、智能所研究员刘斌美向《中国科学报》介绍,葵花籽内部霉变是生产和消费面临的难题。
事实上,近几十年来,农产品特别是粮食作物的霉变风险已受到全球关注。然而,以葵花籽为代表的油料种子研究明显落后于粮食作物。
刘斌美认为:“弄清楚葵花籽内霉如何发生是检测和防控的基础,目前国内外这方面研究基本是空白,因此这项工作显得尤为迫切和重要。”
值得一提的是,课题组已成功开发了粮食品质检测平台,葵花籽等坚果内部霉变程度和品质的无损检测方法也在开发中。
迄今为止,此前研究只是选取了市场上销售的葵花籽作为研究对象,并且这些研究往往仅对其外壳或者籽仁表面携带的微生物进行检测,而忽略了内生微生物。
智能所科研团队这项工作的主要目标,就是通过研究整个葵花籽生产周期中微生物群落的变化和内霉发生之间的关系,探索内部霉变的可能来源以及重要的影响因素,从而为葵花籽安全生产提供技术支撑。
内霉主要发生在田间种植期
内蒙古自治区是中国最大的向日葵产区,巴彦淖尔市素有“中国向日葵之乡”的美誉。
2018年到2020年,智能所团队在巴彦淖尔的葵花籽厂采集了大量收获进仓及储藏后形成内霉的葵花籽样品。
随后,团队利用高通量测序技术,对采集的葵花籽菌群群落特征进行精准表征,研究内霉发生发展与微生物群落结构变化之间的关系,揭示了内霉菌群的来源及相关影响因素。
研究结果表明,内霉葵花籽仁的真菌(包含外生和内生菌)以田间真菌为主,其中链格孢属菌是导致葵花籽内霉发生的“优势”致霉菌。
葵花籽内霉主要发生在田间种植期。论文第一作者、智能所博士研究生刘洁解释说:“通常种子在发育阶段会被链格孢属菌侵染,并且田间潮湿条件为其繁殖提供了有利条件,当侵染达到一定程度即形成内霉。”
研究还发现,葵花籽在安全阈值以下储藏超过6个月,微生物群落结构几乎没有改变,籽仁保持正常外观。但当温湿度条件超过安全阈值,伴随着微生物群落结构的变化,籽仁开始出现内霉,霉变程度随环境湿度与储藏真菌丰度的增加不断加重。
适当田间管理是首要方向
如何有效防控葵花籽内霉发生?刘斌美认为,由于内部霉变主要发生在大田种植阶段,因此对链格孢属菌的田间管理是首要方向。
此外,虽然在主产地葵花籽内霉以在田间种植期发生为主,但也应该预防与储藏相关的真菌的发生。由于短期暴露于高湿度环境下,会迅速增加葵花籽内霉的生长,因此环境除湿必不可少。
“物理防控初步研究结果表明,对于含水量较大或相对湿度较高的非主产区种子,储藏前通过γ 射线辐照等物理辐照处理方式,可以有效地减少或预防内霉的发生。”刘洁表示。
了解清楚葵花籽内霉发生的原因是第一步。接下来,团队将研究如何有效防控和检测内霉,比如改变栽培方式、研发新型药剂、培育抗性品种,以及发展生物光谱无损检测技术等。
对于这项研究,审稿人认为其“具有重要的理论意义和实践意义,对相关研究领域作出积极贡献”。
相关论文信息:https://doi.org/10.3390/microorganisms10071434